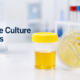

In today’s fast-paced lifestyle, convenience and accuracy in healthcare services have become essential. One of the most sought-after services is blood test home collection in Gurgaon, as it saves time and ensures comfort for patients. When it comes to choosing a reliable service provider, Trutest has emerged as a preferred name and is also recognized as the best diagnostic center in gurugram. Many people searching for blood test home collection in Gurgaon often look for trust, affordability, and professional service, and this is exactly where Trutest stands out.

The biggest advantage of opting for blood test home collection in Gurgaon is the convenience it offers. Instead of traveling to a diagnostic center and waiting in long queues, patients can schedule their tests from the comfort of their homes. Trutest makes the process seamless by providing flexible booking options and timely sample collection.
For working professionals, elderly patients, and individuals with mobility issues, blood test home collection in Gurgaon is a highly beneficial service. Trutest ensures that the entire process is smooth, from booking to report delivery, making healthcare accessible and stress-free.
One of the key reasons to choose Trutest for blood test home collection in Gurgaon is the availability of trained and certified phlebotomists. Sample collection requires precision and hygiene, and Trutest ensures that all professionals are well-trained to maintain high standards.
When you book a blood test home collection in Gurgaon with Trutest, you can be assured that the sample collection will be done safely and efficiently. This reduces the risk of errors and ensures accurate test results, which is crucial for proper diagnosis and treatment.
Accuracy is the most important factor when it comes to diagnostic services. Trutest uses advanced technology and modern laboratories to ensure precise results. People searching for blood test home collection in Gurgaon often prioritize accuracy, and Trutest meets this expectation consistently.
Reliable results help doctors make informed decisions, and that is why choosing the right provider for blood test home collection in Gurgaon is critical. Trutest maintains strict quality control measures, ensuring that every test result is dependable.
Another advantage of choosing Trutest is the wide range of diagnostic tests available. From routine blood tests to specialized screenings, Trutest offers comprehensive services under one platform. This makes it easier for patients looking for blood test home collection in Gurgaon to get all their tests done without hassle.
Whether it is a basic health checkup or a specific test recommended by a doctor, Trutest covers all requirements. This versatility makes it a preferred option for blood test home collection in Gurgaon among individuals and families.

Booking a blood test home collection in Gurgaon with Trutest is simple and user-friendly. Patients can schedule appointments online or through a phone call. The process is designed to be quick and efficient, saving time and effort.
Trutest understands the importance of convenience in healthcare, and that is why the booking system for blood test home collection in Gurgaon is streamlined. Patients receive confirmation instantly, and the sample collection is scheduled at their preferred time.
Time is a crucial factor in medical testing. Trutest ensures that sample collection for blood test home collection in Gurgaon is done on time, without unnecessary delays. Punctuality is one of the key strengths that sets Trutest apart from other service providers.
In addition to timely collection, Trutest also focuses on quick report delivery. Patients who opt for blood test home collection in Gurgaon receive their reports within the promised timeframe, enabling faster diagnosis and treatment.
Cost is often a concern when choosing diagnostic services. Trutest offers competitive pricing for blood test home collection in Gurgaon, making quality healthcare accessible to a wider audience. Transparent pricing ensures that there are no hidden charges, which builds trust among customers.
Many people compare different providers for blood test home collection in Gurgaon, and affordability becomes a deciding factor. Trutest strikes the perfect balance between cost and quality, making it a reliable choice.
In today’s health-conscious environment, maintaining hygiene is extremely important. Trutest follows strict safety protocols during blood test home collection in Gurgaon. From using sterilized equipment to following proper disposal methods, every step is handled with care.
Patients opting for blood test home collection in Gurgaon can feel safe knowing that Trutest prioritizes hygiene. This is especially important for preventing infections and ensuring a safe testing process.
Good customer service plays a vital role in healthcare services. Trutest provides excellent customer support for individuals booking blood test home collection in Gurgaon. Whether it is assistance with booking, test selection, or report queries, the support team is always available to help.
Having reliable support enhances the overall experience of blood test home collection in Gurgaon. Trutest ensures that every customer receives prompt and helpful responses to their queries.
Regular health checkups are essential for early detection of diseases. Blood test home collection in Gurgaon makes it easier for individuals to monitor their health without disrupting their daily routine. Trutest encourages preventive healthcare by offering convenient testing services.
By choosing blood test home collection in Gurgaon, individuals can stay proactive about their health. Trutest supports this approach by providing accessible and reliable diagnostic services.

Choosing the right provider for blood test home collection in Gurgaon is essential for accurate results, convenience, and peace of mind. Trutest stands out due to its professional service, reliable results, affordable pricing, and customer-focused approach.
With trained phlebotomists, advanced technology, and a commitment to quality, Trutest has become a trusted name for blood test home collection in Gurgaon and a reliable blood test center in gurgaon Whether you need routine testing or specialized diagnostics, Trutest ensures a smooth and hassle-free experience.
For anyone looking for dependable blood test home collection in Gurgaon, Trutest is a smart and reliable choice that combines convenience, accuracy, and affordability.